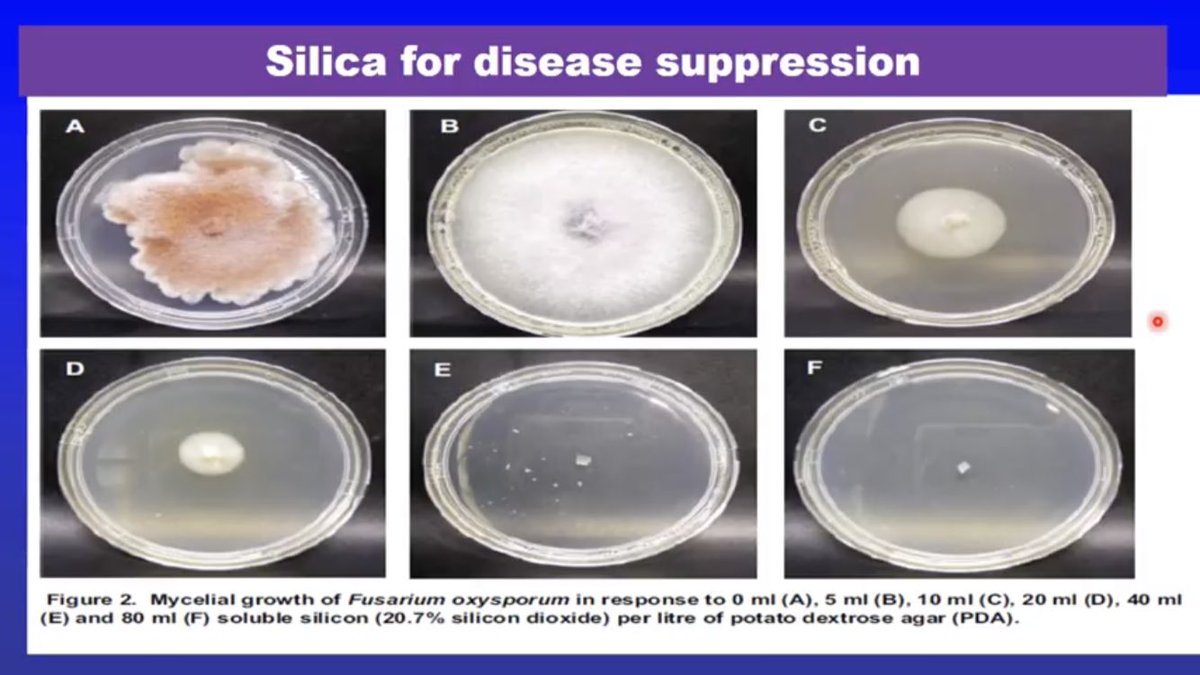
Dave Edmondson tweet media

@DPWTQSchool @DPWorldTour Welcome back Eddie - we missed you -,DeirdreN
English
deirdre nolan
56 posts
















There may have been a little bending in the final round, but @leona_maguire did not break! She wins the 2019 @Symetra Classic at 10-under par overall highlighted by a bogey-free, 5-under par 67 this afternoon #Congratulations #SymetraClassic #Road2LPGA #DriveOn